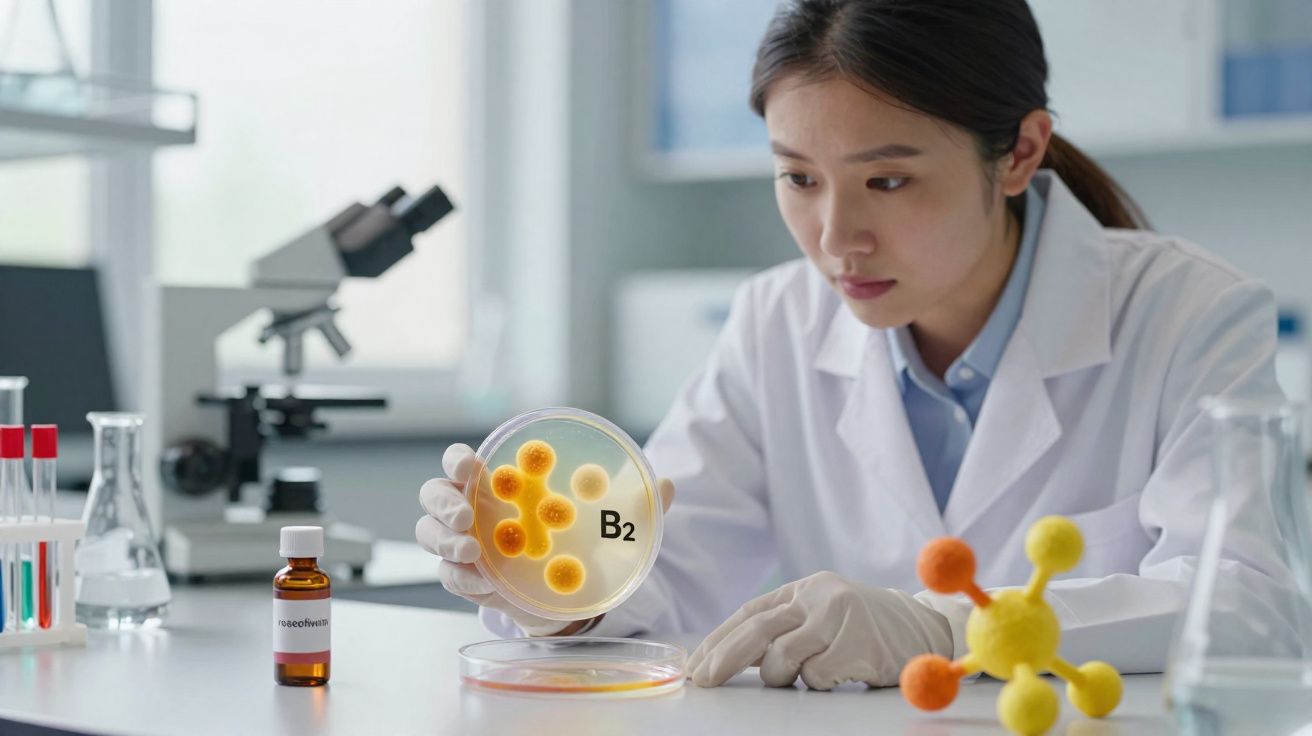
Cientista em laboratório a examinar placa de Petri com colónias laranjas marcadas com B2.

Um futuro mais quente soa a má notícia para as florestas - e, muito provavelmente, é mesmo. Ainda assim, uma nova experiência indica que, para muitas árvores, o maior perigo não é a temperatura por si só. O problema aparece quando o calor vem acompanhado de solo seco.
O estudo, conduzido pelo Instituto Federal Suíço de Investigação para a Floresta, Neve e Paisagem (WSL) e pela EPFL, assenta numa instalação rara e de longa duração em Birmensdorf, perto de Zurique.
Há mais de cinco anos, faias jovens e carvalhos-pubescentes têm crescido em câmaras climáticas onde os investigadores conseguem aumentar a temperatura, reduzir a água disponível ou aplicar ambas as pressões em simultâneo.
A lógica foi direta: reproduzir o tipo de verões que a Europa Central poderá enfrentar se o aquecimento atingir cerca de +5 °C (9 °F) e observar, de forma concreta, o que acontece às folhas.
O resultado é, em certa medida, contraintuitivo: quando existe água disponível, as folhas aguentam temperaturas surpreendentemente elevadas; mas, se o mesmo calor ocorrer durante uma seca, podem sofrer danos permanentes.
Dentro de um teste de mini-floresta: faia e carvalho-pubescente
Nas instalações do WSL, a equipa construiu câmaras de topo aberto - na prática, pequenos “ecossistemas-modelo” ao ar livre. Lá dentro, as mudas crescem sob combinações cuidadosamente controladas de temperatura do ar e humidade do solo.
Um conjunto de árvores manteve-se com temperatura e rega normais. Outro grupo cresceu em ar mais quente - cerca de 5 °C (9 °F) acima do exterior - para simular um cenário climático futuro.
Um terceiro grupo foi sujeito a condições de seca. E o tratamento mais exigente juntou os dois fatores: ar mais quente e solo seco ao mesmo tempo.
O trabalho incidiu sobre duas espécies com enorme importância na Europa Central. A faia é muito comum e tem peso económico, mas sabe-se que sofre com a seca - sobretudo quando ainda é jovem.
O carvalho-pubescente é diferente: é mais típico de climas de tipo mediterrânico, mas também existe na Suíça, sendo frequentemente apontado como uma possível árvore “substituta” para condições mais quentes.
“Queríamos comparar a sua estratégia de uso de água com a da faia, uma árvore mais sensível às secas, especialmente na fase de muda”, disse Alyssa Therese Kullberg, ecofisiologista vegetal na EPFL e no WSL, que liderou o trabalho.
Como as árvores controlam o calor
As folhas aquecem mais depressa do que muitas pessoas imaginam. Sob sol direto, a superfície foliar pode chegar facilmente aos 40 a 45 °C (104 a 113 °F), mesmo que o ar esteja mais fresco.
Em geral, as árvores protegem-se com um “truque” semelhante a suar nas plantas: a transpiração. As folhas libertam vapor de água por poros microscópicos, arrefecendo a superfície à medida que a água evapora.
Mas este mecanismo só funciona se houver água suficiente no solo. Quando a seca se instala, as árvores enfrentam uma escolha difícil.
Podem manter os poros abertos para arrefecer as folhas, arriscando ficar sem água e comprometer a planta inteira. Ou podem fechar os poros para poupar água - e, nesse caso, o arrefecimento abranda ou desaparece, deixando as folhas aquecerem muito.
Nesta experiência, os investigadores acompanharam a temperatura das folhas e procuraram sinais visíveis de dano, incluindo alterações de cor. Quando a água não faltava, mesmo calor extremo não se revelou a catástrofe que se poderia antecipar.
“Podemos ver um pouco de queimadura solar nas folhas, com danos ligeiros no sistema de fotossíntese, mas esses danos são normalmente temporários”, afirmou Kullberg.
Assim, o calor por si só - mesmo quando as folhas entravam em zonas desconfortáveis - tendia a provocar apenas stress de curta duração. A situação mudava quando entrava em cena a seca.
A seca torna o calor perigoso para as árvores
Com o solo seco, as folhas não conseguem continuar a evaporar água sem pôr a árvore em risco. Por isso, os poros fecham, a transpiração diminui ou pára, e a temperatura foliar sobe ainda mais.
É então que aparece o “escaldão”: manchas castanhas de tecido morto ou com dano irreversível.
Os investigadores observaram que ultrapassar a “margem de segurança térmica” de uma folha - um limiar crítico de temperatura - estava associado a dano duradouro, sobretudo em contexto de seca.
A equipa recorreu também a dados experimentais controlados para mostrar que exceder essas margens de segurança térmica pode causar escaldão permanente, em especial quando a água é escassa.
“É por isso que estamos mesmo entusiasmados com esta descoberta”, disse Kullberg.
O carvalho-pubescente supera a faia em situação de seca
A faia apresentou sinais claros de sofrimento. Nas mudas de faia, a combinação de calor e seca levou frequentemente a folhas escaldadas, com manchas castanhas a alastrarem pela superfície.
O carvalho-pubescente não reagiu da mesma forma - e é aqui que o estudo se torna particularmente revelador.
“Não vimos muito escaldão nas folhas de carvalho, apesar de as suas margens de segurança térmica terem sido ultrapassadas praticamente com a mesma frequência que as das folhas de faia”, afirmou Kullberg.
“Ou seja, ambas as espécies atingiram temperaturas críticas com a mesma regularidade, mas o carvalho pareceu tolerar melhor essas condições. Isso foi uma surpresa e não pode ser totalmente explicado pelos mecanismos que medimos no nosso estudo.”
Em termos simples, carvalho e faia atingiram temperaturas “demasiado altas” a ritmos semelhantes, mas as folhas de faia pagaram um preço muito maior. As do carvalho, por algum motivo, resistiram melhor.
A equipa ainda não consegue esclarecer totalmente o porquê, o que é uma ressalva importante. Ainda assim, o resultado tem peso porque separa dois aspetos que muitas vezes são tratados como se fossem o mesmo: chegar a uma temperatura crítica e sofrer dano por causa dela.
O papel discreto do ar seco
Há ainda outro elemento: seca não significa apenas “menos chuva”. Mesmo que a precipitação se mantenha, o aquecimento, por si só, pode tornar os solos efetivamente mais secos.
A razão é que o ar quente consegue conter mais humidade. À medida que as temperaturas sobem, aumenta a “procura” atmosférica por água - o ar retira mais humidade do solo e das folhas através da evaporação.
Assim, as florestas podem entrar em stress hídrico mais cedo, mesmo sem alterações dramáticas na precipitação. Esta é uma das razões pelas quais se espera um aumento do risco de seca com as alterações climáticas.
Por exemplo, na Suíça, os verões quentes e secos de 2018 e 2022 causaram escaldão generalizado nas folhas de faia. O fenómeno foi particularmente marcado em zonas onde os solos já eram secos. A experiência ajuda a perceber por que motivo isso acontece.
Com água disponível, a faia consegue manter-se fresca. Mas, quando o solo seca, é forçada a desligar o seu sistema de arrefecimento foliar - e o calor torna-se muito mais perigoso.
Testar árvores ao longo do tempo
As árvores nas câmaras climáticas vão continuar a crescer nestas condições controladas por mais dois anos. Isso dá à equipa a oportunidade de explorar uma pergunta de seguimento relevante para florestas reais: as árvores “aprendem” com o stress?
Por outras palavras, se uma árvore já passou por escassez de água, ajusta-se de forma a aumentar a sobrevivência perante futuras ondas de calor e secas?
Com mais anos de registos, os investigadores poderão testar se o stress anterior torna as árvores mais resistentes - ou se, pelo contrário, as deixa simplesmente mais debilitadas.
Para gestores florestais, a mensagem já parece inequívoca: o aquecimento é um problema, mas a água é o rastilho.
Se ondas de calor e secas se tornarem ambas mais frequentes, a sobrevivência das árvores dependerá menos de quão quente fica o ar. Dependerá mais de existir água suficiente no solo para impedir o sobreaquecimento das folhas.
As diferenças entre espécies, como a faia e o carvalho-pubescente, podem influenciar a aparência das florestas de amanhã, mesmo em regiões onde a faia dominou durante séculos.

Comentários
Ainda não há comentários. Seja o primeiro!
Deixar um comentário